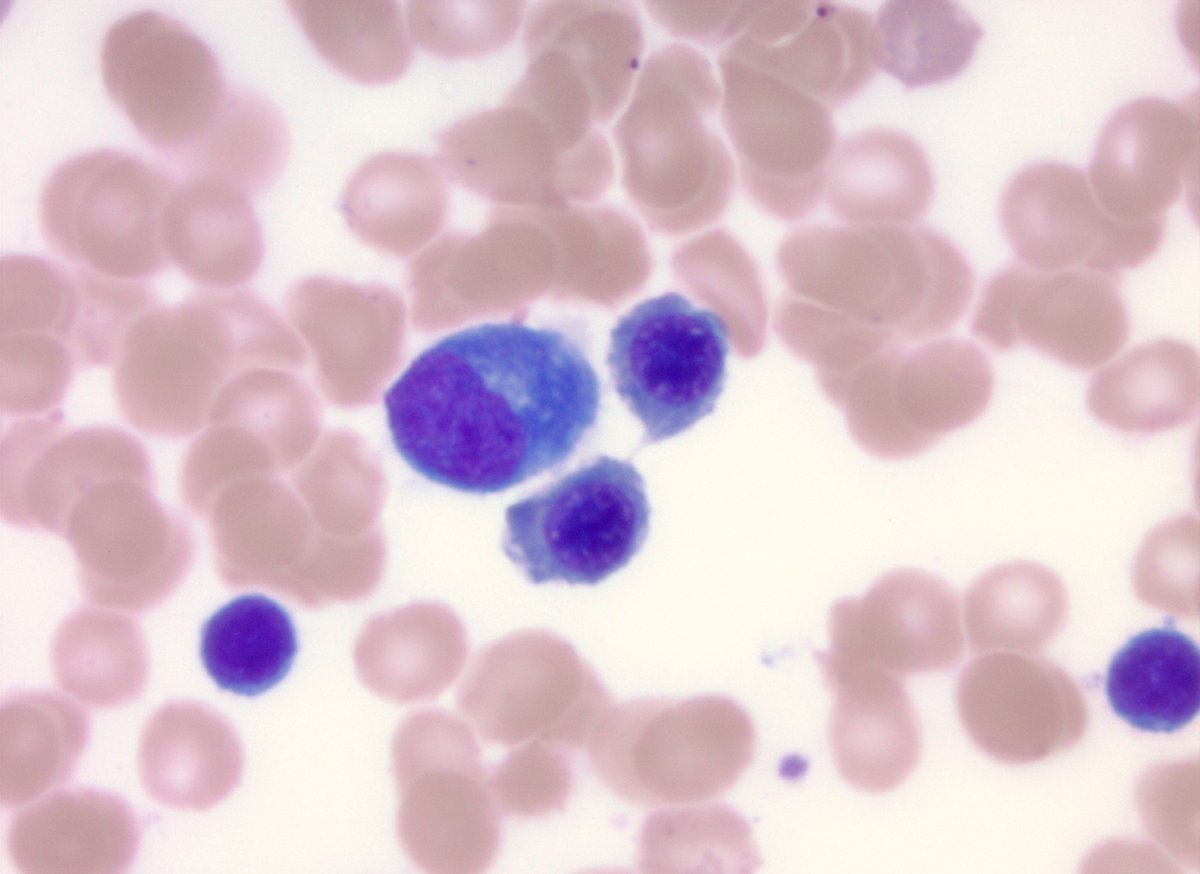
Jake Bledsoe tweet media
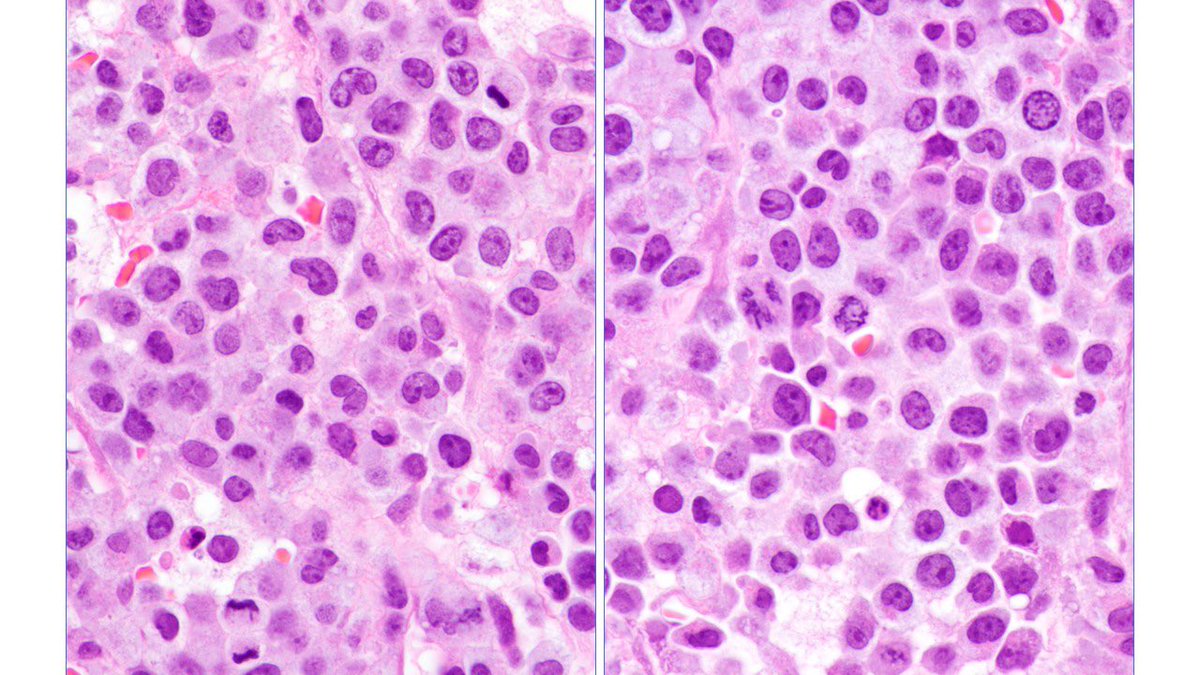
Judith Ferry tweet media

Sabitlenmiş Tweet

A GROUNDING article…one of the very best and a must read.
Stop chasing the damn moon.
‘War on cancer”
‘together we can conquer cancer in our lifetime’
If it ain’t “broken”, no need for a “fix”
“ComPARe study” @AHS_CancerCare @oncology_bg
apple.news/A2jQC5YPIRUCxV… @oncology_bg
English